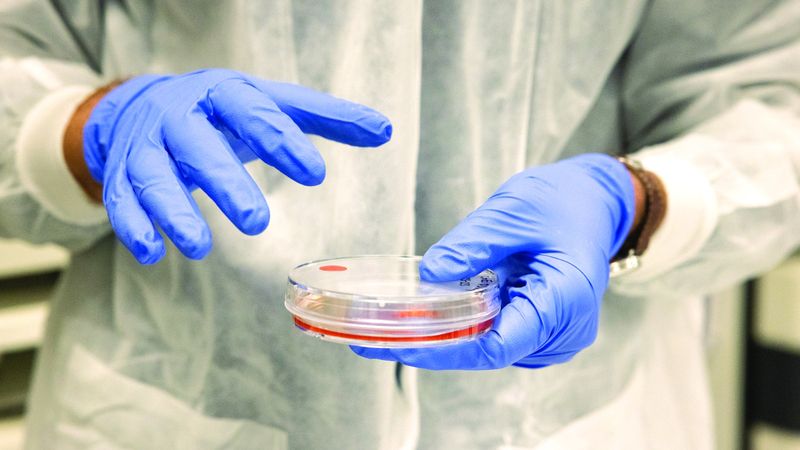

فتح النجاح الذي حققه باحثون للمرة الأولى في إنتاج بويضات نسائية مخبرياً من خلايا أخرى، الباب أمام إمكان التوصل بهذه الطريقة إلى علاج العقم، ومع أن هذه التجربة لاتزال في بداياتها، تثير هذه الأبحاث منذ الآن مسائل مهمة تتعلق بالأخلاقيات، وأورد باحثون في دراسة، نُشرت هذا الأسبوع، في مجلة «نيتشر كوميونيكيشنز»، تفاصيل عن كيفية تحويلهم خلايا الجلد إلى بويضات قابلة للتخصيب، ويُشكّل نجاح هذه التجربة خطوة مهمة لتحقيق فكرة لاتزال إلى اليوم مجرّد خيال علمي، وهي علاج العقم لدى بعض النساء غير القادرات، أو اللواتي لم يعدن قادرات على إنتاج البويضات، عن طريق تكوين هذه البويضات من خلايا أخرى.
إلا أن دراسة مجلة «نيتشر» تذهب إلى أبعد من ذلك بكثير، فهذه المرة استُخدِمَت في التجارب خلايا بشرية، لدرجة أنها تطوّرت إلى أجنّة، مع أنها سرعان ما دُمّرت.
وبادر الباحثون المقيمون في الولايات المتحدة إلى إزالة النوى من البويضات، والاستعاضة عنها بأخرى مأخوذة من خلايا الجلد، ومن المعروف أن هذه التقنية التي تحمل تسمية «النقل النووي»، تتيح منذ مدة طويلة استنساخ الحيوانات من دون إخصاب، مثل النعجة دوللي الشهيرة عام 1996، ثم حاولوا تخصيب هذه الخلايا، ومن بين هذه البويضات المرشحة للتخصيب، تطورت نحو 10 إلى أجنة بعُمر بضعة أيام، وبلغت تالياً مرحلة يمكن فيها نظرياً زرعها في مريضة بوساطة التلقيح الصناعي.
تابعوا آخر أخبارنا المحلية والرياضية وآخر المستجدات السياسية والإقتصادية عبر Google news
ملحوظة: مضمون هذا الخبر تم كتابته بواسطة الامارات اليوم ولا يعبر عن وجهة نظر مصر اليوم وانما تم نقله بمحتواه كما هو من الامارات اليوم ونحن غير مسئولين عن محتوى الخبر والعهدة علي المصدر السابق ذكرة.